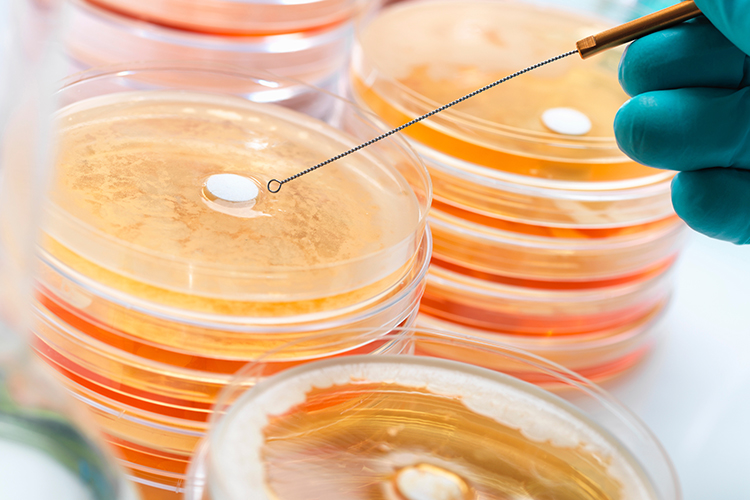

食品微生物實(shí)驗(yàn)室介紹
食品微生物實(shí)驗(yàn)室主要承擔(dān)《食品微生物學(xué)》和《有害微生物檢測(cè)與控制技術(shù)》等課程實(shí)驗(yàn)實(shí)訓(xùn)教學(xué)工作����,主要開(kāi)展顯微鏡使用、細(xì)菌染色�����、細(xì)菌形態(tài)觀察�、微生物分離純化、微生物轉(zhuǎn)種接種����、菌落總數(shù)的測(cè)定等試驗(yàn);實(shí)驗(yàn)室配備常用設(shè)備儀器有:高壓滅菌鍋�����、恒溫培養(yǎng)箱�����、恒溫振蕩器等..…